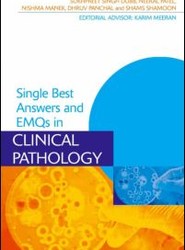
Single Best Answers and EMQs in Clinical Pathology

(To see other currencies, click on price)
MORE ABOUT THIS BOOK
Main description:
The second edition of Single Best Answers in Surgery, Second Edition continues to provide invaluable guidance to this widely used question format, written by authors who understand that detailed explanations accompanying each answer are the key to a successful revision aid.
This book presents more than 500 SBA questions arranged into topic areas as well as a section of random questions for self-testing under examination conditions. A clear discussion of how the correct answer was reached and other options ruled out for every question is given at the end of each section, making this book an excellent learning aid for all stages of undergraduate surgical studies, and particularly during revision for final examinations.
Contents:
Applied Anatomy. Pre- and Postoperative Management. Fluid Balance and Nutrition. Anaesthetics and Surgical Critical Care. Trauma. Abdomen: Upper Gastrointestinal and Hepatobiliary Surgery. Abdomen: Lower Gastrointestinal Surgery. Abdomen: The Acute Abdomen. Breast Surgery and Endocrine Disease. Vascular Surgery. Urology. Orthopaedics. Neurosurgery. ENT Surgery. Ophthalmic Surgery. Lumps, Bumps, Skin and Hernias. Practice Exam.
PRODUCT DETAILS
Publisher: Taylor & Francis (Routledge)
Publication date: October, 2014
Pages: 448
Weight: 771g
Availability: Available
Subcategories: General, Medical Study and Teaching Aids
From the same series